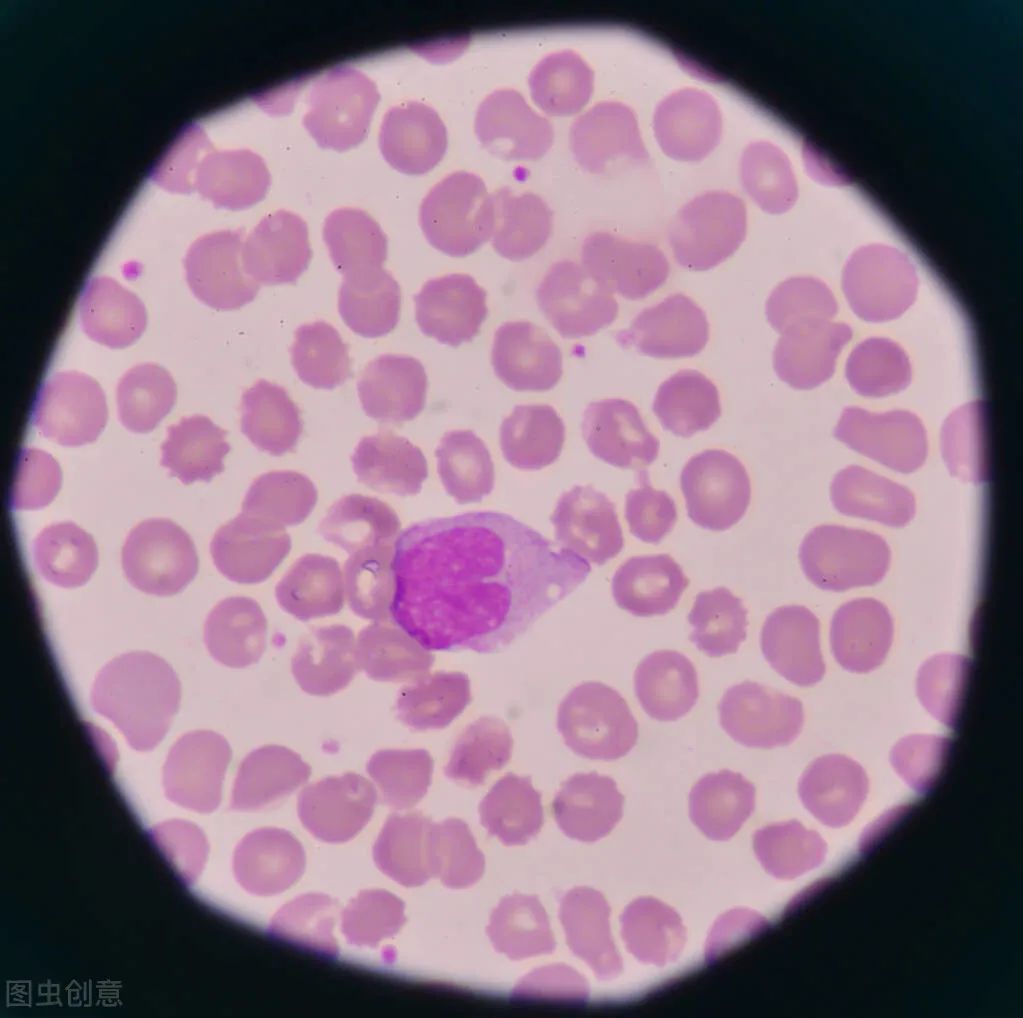
嗜酸性粒细胞升高是怎么回事? 嗜酸性粒细胞升高是怎么回事?
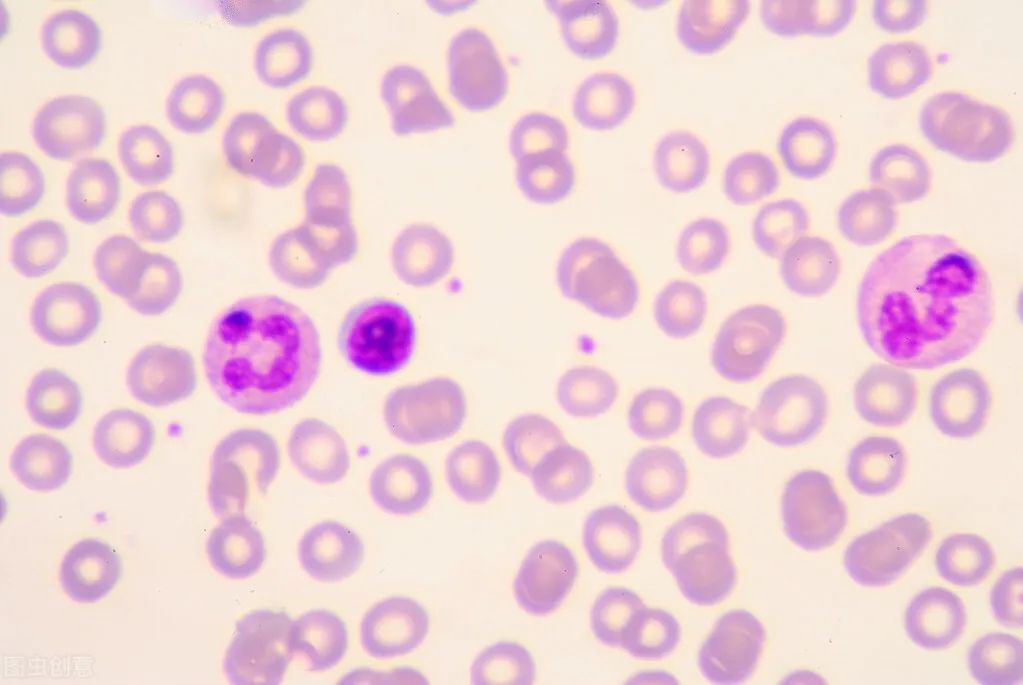
嗜酸性粒细胞升高是怎么回事? 嗜酸性粒细胞升高是怎么回事?

什么是嗜酸性粒细胞?
嗜酸性粒细胞是粒细胞系统中的重要组成部分,由骨髓干细胞所产生的,嗜酸性粒细胞具有吞噬的作用,可以吞噬多种物质,比如酵母细胞,吞噬抗原、细菌。嗜酸性粒细胞呈圆形,直径 13~15μm。胞质内充满粗大、整齐、均匀、紧密排列的砖红色或鲜红色嗜酸性颗粒,折光性强。细胞核的形状与嗜中性白细胞相似,通常有 2~3 叶,呈眼镜状,深紫色。那么它具体长的怎样呢?下面这张图就是嗜酸性粒细胞真实的样子!
嗜酸性粒细胞都见于哪些疾病?
嗜酸性粒细胞升高可见于下列疾病:
(1)变态反应性疾病如支气管哮喘、荨麻疹、药物过敏、过敏性紫癜、血管神经性水肿等。
(2)寄生虫感染如血吸虫病、蛔虫病、钩虫病等。
(3)某些皮肤病如湿疹、剥脱性皮炎、天疱疮、银屑病等。
(4)某些血液病如慢性粒细胞白血病、多发性骨髓瘤、嗜酸粒细胞白血病、淋巴瘤、嗜酸性粒细胞肉芽肿等。
(5)某些恶性肿瘤某些上皮系肿瘤如肺癌等。
(6)某些传染病如猩红热等。
(7)其他风湿性疾病、脑腺垂体功能减低症、肾上腺皮质功能减低症、过敏性间质性肾炎等。
怎么正确的判断嗜酸性粒细胞升高呢?
正常值参考范围
嗜酸性粒细胞数量占白细胞总数的百分比:0.5%~5%
特发性嗜酸性粒细胞增多综合征的诊断标准:
外周血嗜酸性粒细胞>1.5×109/L,并持续6个月以上,或出现临床症状后,于6个月内死亡。临床症状可表现为发热、皮疹、乏力、咳嗽、气短、肌肉酸痛,或腹泻等。体格检查可发现皮疹、淋巴结肿大、肝脾肿大、肺内啰音、腹部压痛或神经系统异常等。

如果存在危及生命的器官受损(例如心肌缺血和呼吸衰竭),则无需进行第二次嗜酸性粒细胞计数检查即可建立初步诊断,以便及时治疗。
嗜酸性粒细胞偏高应该如何进行治疗?
治疗应寻找病因进行治疗,在进行性器官系统功能异常发生前是不必处理的,患者每隔3~6个月作一般性检查一次.对器官系统的并发症应积极治疗。
看了以上的讲解,现在你知道嗜酸性粒细胞百分比偏高是怎么回事了吧。如有发现嗜酸性粒细胞百分比偏高,要尽早检查,确诊病因哦。
变态反应科 马婷婷 图片来源于网络

